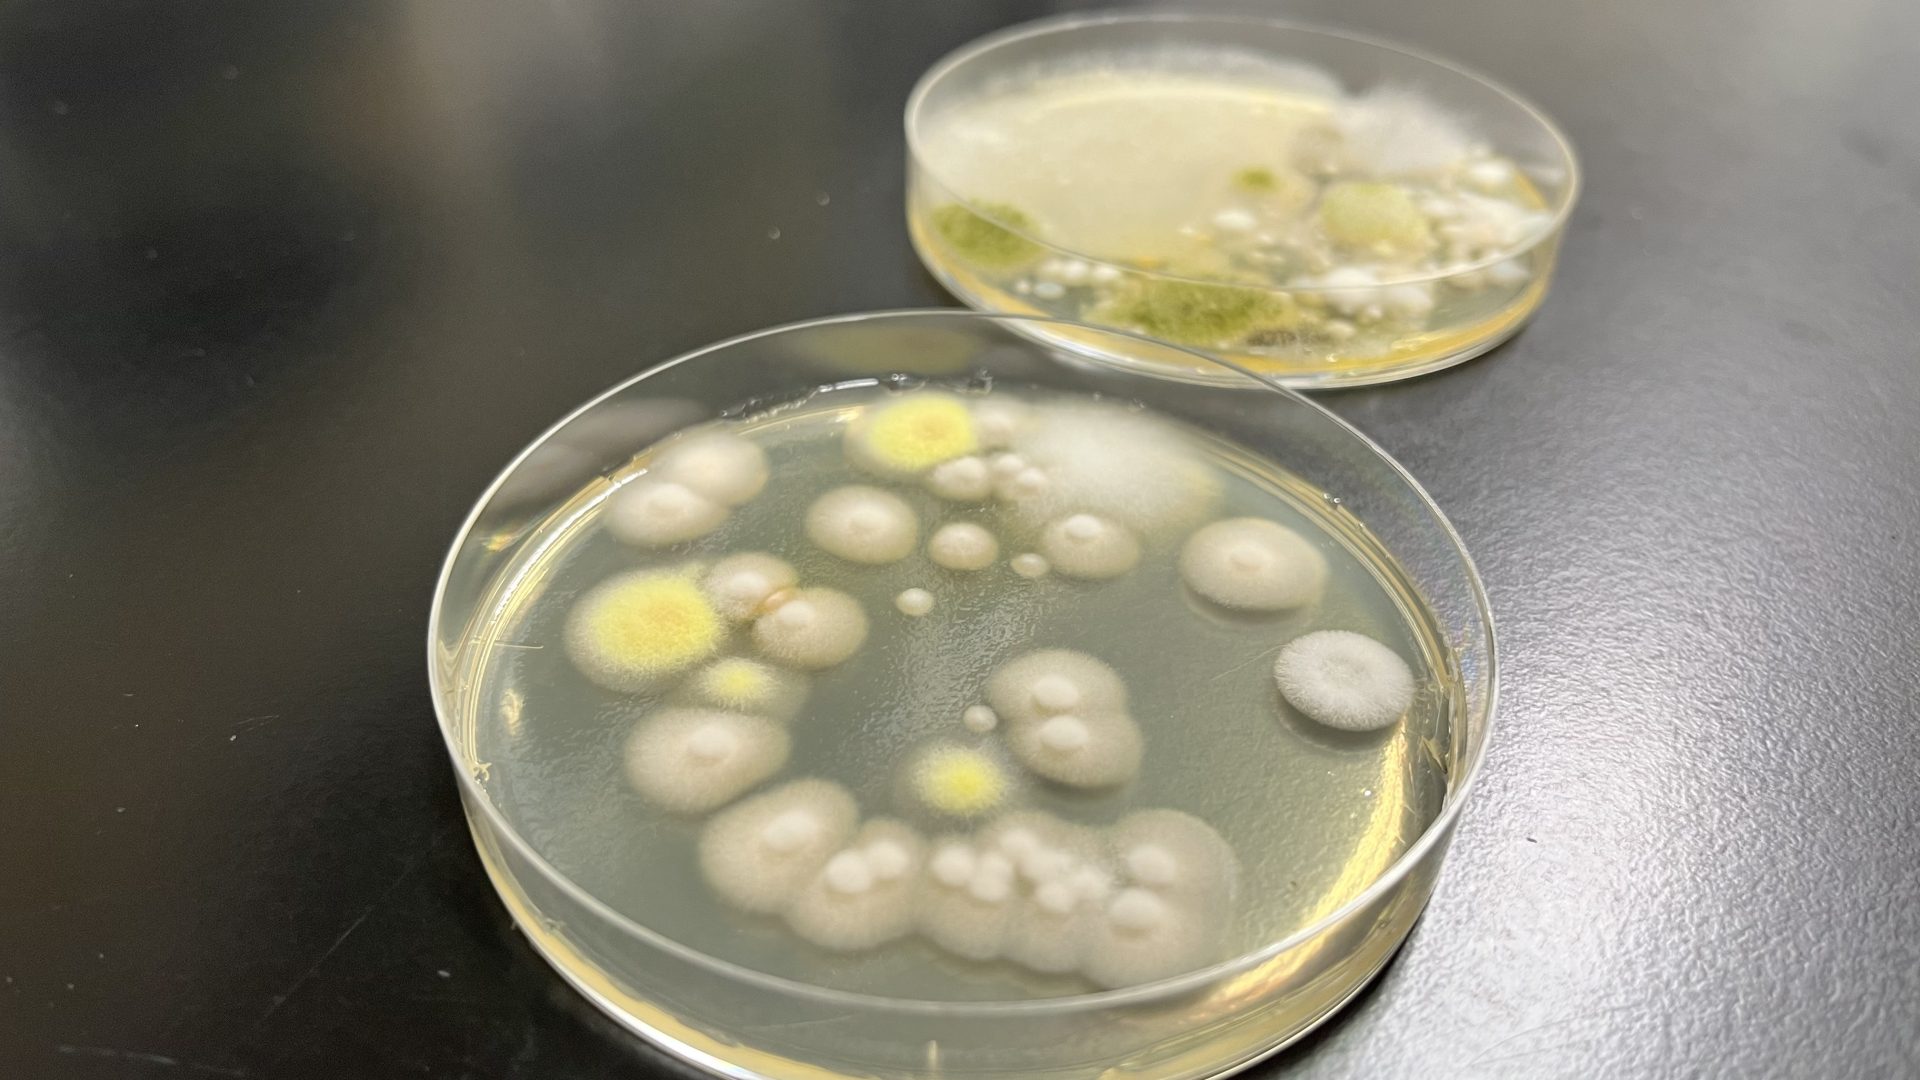

2023年5月
微生物でつくる新しい未来
~地球に良いプラスチックの実現~(後編)
前編では、微生物があらゆる社会問題を解決した事例に触れながら、微生物が持つ可能性について麻生教授に伺いました。
後編では、全国から集めてきた数十億という微生物の中から、有効な微生物だけをどうやって瞬時に抽出するのか、その技術について伺います。
数十億のなかから「有効な微生物」だけを瞬時に発見する技術
全国から様々な土のサンプルを集めるのも大変ですが、それ以上に難しいのが、その中から有効な微生物、つまりプラスチック原料となる「代謝物」を作る微生物だけを抽出する作業です。1つのサンプルに数十億もの微生物が存在し、そのサンプルが無数にあるとなると、それらを一つ一つ分析していては時間がどれだけあっても足りません。
これらの問題を解決できるのが、今から紹介する技術です。一言でいうなら「採取した土をまるごとスクリーニング(目的の微生物を探し出す操作)にかけて、目的の微生物とそうでない微生物を選別する技術」です。
プラスチック原料と同じ構造を持つ「代謝物を作る微生物」を探し出す
身の回りにあるプラスチックの原料の構造は、以下のように末端が二重結合になっているものがあります。

微生物の世界を覗いてみると、実は「末端が二重結合になっている代謝物を生み出す微生物(以降「末端二重結合を作る微生物」と表記)」が存在していることが分かりました。この微生物こそがまさにプラスチックの原料を生み出す微生物なのです。つまり、大量の微生物のなかから、「末端二重結合を作る微生物」だけを抽出することができれば良いということです。
そこで私が開発した以下の2種類のスクリーニング技術を使って選別していくことになります。
①チオールーエン反応を使ったスクリーニング技術
②ヘック反応を使ったスクリーニング技術
①チオールーエン反応を使ったスクリーニング技術
1つ目の「チオールーエン反応を使ったスクリーニング」はいたってシンプルです。
1. チオグリセロールという試薬を入れた寒天培地に、採取した土を塗って土の中の微生物を培養します。

2. 微生物が増えて寒天培地にコロニーができれば、その微生物が「末端二重結合を作る微生物」です。
この試薬にさらされると、チオグリセロールが持つ抗菌機能で通常の微生物は死滅してしまいます。
しかし「末端二重結合を作る微生物」がいると、ある化学反応が起こり、チオグリセロールの抗菌機能が消滅するのです。その結果「末端二重結合を作る微生物」は生き残ることができます。
この反応を「チオールーエン反応」と言います。
生き残った微生物は、その後、増殖しコロニーとなり肉眼で認識できる塊となって現れます。
この塊こそが、「プラスチック原料を作る微生物」です。
生き残った目的の微生物は、本来は肉眼で確認できませんが、増殖し塊(コロニー)となることで目ではっきりと確認できます。このようにシンプルかつ分かりやすい点が、この技術の最大の特徴といえます。
②ヘック反応を使ったスクリーニング技術
先ほど抽出した微生物に対してヘック反応という方法を使い、さらに精度の高いスクリーニングをかけています。
このスクリーニングもいたってシンプルです。
1. チオールーエン反応を使って選抜した微生物の培養液にヨードベンゼンとパラジウム触媒を加えて反応させます。

2. そこにデンプンを入れて反応液が青紫色になれば、そこには確かに目的の微生物がいることになります。

これはヘックという博士が見つけたヘック反応を利用しています。ヘック反応とは「ヨウ素を持っている化合物(ヨードベンゼン)と、末端二重結合を持っている化合物が結合する反応」のことを言います。
この方法の優れているところは、デンプンを加えた培養液に末端二重結合を作る微生物がいる場合、反応液が青紫色に変わりすぐに目的の微生物がいると判断できる点です。
「ヨウ素デンプン反応」という言葉を小学校の理科の実験で聞いた方も多いと思います。ヨウ素液をデンプンに垂らすと青紫色に変わるという反応です。これと同じ仕組みを利用しています。
この2つのスクリーニング技術で採取した土をふるいにかけていき、目的の微生物を探し当てます。

どちらの技術もシンプルかつ容易に行えるため時間の圧倒的な節約に繋がり、より多くの時間を土を採取する時間などに使えるのです。
言われれば理解できるが、足を踏み入れるまでは未知の世界
これらのスクリーニング技術はとてもシンプルに聞こえます。しかしコロンブスの卵と同じように「あそこにアメリカ大陸がある!」と言われれば誰もが理解できますが、言われるまでは全くわからない未知の世界です。
先ほど紹介した2つの反応は化学の世界では有名ですが、微生物を扱うバイオ分野ではまず耳にすることがありません。そのためほとんどの研究者が知見を持っておらず、これらの反応を使うという発想自体がありません。
一方で化学の世界では、これらの反応をバイオで使うという発想がなかったため、微生物に応用する技術については知見が全くありませんでした。
このように、お互い全く違う立場にあったバイオと化学の研究を微生物という分野で繋ぎ合わせたということになります。ですので、言われてみると誰もが理解できますが、言われるまでは謎が多い未知の世界だったのです。この2つの分野の技術を掛け合わせた研究は世界唯一と言っていいでしょう。
私もずっとバイオの世界だけにいては、この発想に辿り着けなかったでしょう。
どれだけ考えても方法が見つからない時ほど、一度バカになって見ることが大切だと思っています。
一見、関係のない世界をたくさん覗いてみて、その中にヒントはないだろうか?と自分が知らない世界に飛び込んでみることが大切です。
プラスチックが「人と地球を守る存在」へと変わる
微生物は、私たち人間ができない大きなことをやってのける力を持っています。
ガンをはじめ多くの人を苦しめている病気を治癒する可能性、温暖化や環境破壊を根本的に解決する力など、世界を大きく変えてしまう可能性を秘めています。
目に見えないけれど確かにそこにいる、そんな小さな存在が世界を変えると聞くと少しロマンを感じませんか?
私の使命は、それら微生物が持つ未知なる可能性を1つでも多く解明し、それを世の中の多くの人に届けることだと信じています。
その一つが今回紹介した「微生物を使ったプラスチック開発の研究」です。
私はこの研究を通じてプラスチックそのものの概念を変えたいと思っています。
これまで便利に都合よく人間に使われてきたプラスチックですが、ストローが紙になったりエコバックが主流になった今では、まるで邪魔者のような扱いを受けています。
ですが、どれだけ頑張ったとしてもプラスチックを私たちの暮らしから無くすことは現実的ではありません。今いる場所から周囲を見渡してみてください。プラスチック製のものがどれだけあるか、実感できると思います。プラスチックとの共存は避けることができません。
だからこそ、地球に良いプラスチックを作るのです。
放置されても分解されるプラスチック、海洋ごみにならないプラスチック、燃やしても排出される二酸化炭素の量が少ないプラスチックなど、「プラスチックって環境や体にいいよね」という認識がもたれるような社会を作りたいと思っています。
またプラスチックを、単なる容器や造形としての役割を超えた機能をもつ存在にできればと考えています。
先ほどお伝えしたように抗炎症・抗がんなどの機能を持ったプラスチックが開発できれば、「薬より効果が高く加工しやすい医療材料」として活用するなど、プラスチックの新しい活用方法が見つけられるはずです。
諦めない信念こそがエンジン
正直に言ってしまうと、微生物の研究をしているなかで何度も打ちのめされた経験があります。
学生たちと一緒に日々奮闘しながら研究を進めるなかで、調べても調べても報われない日々が続くことはこれまでもたくさんありましたし、これからもたくさんあるでしょう。
それでも土を集めては微生物を発見し、その構造を調べるということをやり続けます。
そこには一筋の微かな希望を信じ抜くような信念があるからです。これが「きっと世の中の多くの人の役にたつ」「地球をより良い方向に変える」はずだと信じながら日々研究に向かっています。
そうやっていると必ず、それまでの努力や苦労が報われる「可能性を秘めた発見」に出会えるのです。
先日も学生が持ってきた研究結果を数日間眺めているうちに、「これは使える!」という発見に出会えました。このときの喜びはなににも変えられません。学生たちもとても嬉しそうですし、学生たちの努力が報われたことに私もほっと胸を撫で下ろします。
地道ではありますが、微生物が持つ可能性をこれからも追いかけ続けたいと思います。
研究者プロフィール

主な発表論文・関連特許
DISCOVER: A facile structure-based screening method for vinyl compound producing microbes
著者名 : Y. Aso*, M. Sano, H. Kuroda, H. Ohara, H. Ando, K. Matsumoto.
掲載誌名 : Sci. Reports
出版年月 : 2019年
巻・号・頁 : 9(1), 16007
Microbial screening based on the Mizoroki-Heck reaction permits exploration of hydroxyhexylitaconic-acid-producing fungi in soils
著者名 : M. Sano, R. Yada, Y. Nomura, T. Kusukawa, H. Ando, K. Matsumoto, K. Wada, T. Tanaka, H. Ohara, Y. Aso*掲載誌名 : Microorganisms
出版年月 : 2020年
巻・号・頁 : 8(5), 648
Biobased poly(itaconic acid-co-10-hydroxyhexylitaconic acid)s: Synthesis and thermal characterization
著者名 : Y. Aso*, M. Sano, R. Yada, T. Tanaka, T. Aoki, H. Ohara, T. Kusukawa, Matsumoto, K. Wada
掲載誌名 : Materials
出版年月 : 2020年
巻・号・頁 : 13(12), 2707
Production of R– and S-1,2-propanediol in engineered Lactococcus lactis
著者名 : R. Sato, M. Ikeda, T. Tanaka, H. Ohara, Y. Aso*
掲載誌名 : AMB Exp.
出版年月 : 2021年
巻・号・頁 : 11, 117
- 産学連携や研究支援に興味がある方(産学公連携推進センターHP)
- 紹介教員にメッセージを送りたい方(メッセージフォーム)
- 大学や学生を支援したい方(基金事業)
- 受験を考えている方(入試情報)
- 大学全体について知りたい方(京都工芸繊維大学HP)




